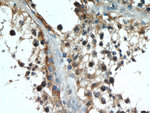
AMH Antibody in Immunohistochemistry (Paraffin) (IHC (P))
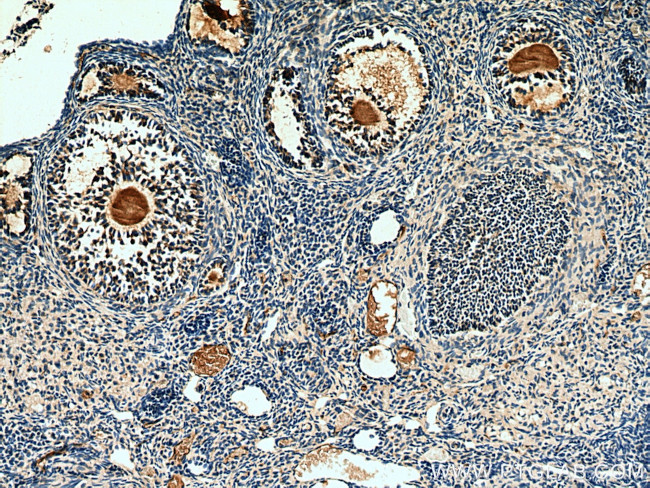
AMH Antibody in Immunohistochemistry (Paraffin) (IHC (P))

Search
Proteintech
AMH Polyclonal Antibody
{{$productOrderCtrl.translations['antibody.pdp.commerceCard.promotion.promotions']}}
{{$productOrderCtrl.translations['antibody.pdp.commerceCard.promotion.viewpromo']}}
{{$productOrderCtrl.translations['antibody.pdp.commerceCard.promotion.promocode']}}: {{promo.promoCode}} {{promo.promoTitle}} {{promo.promoDescription}}. {{$productOrderCtrl.translations['antibody.pdp.commerceCard.promotion.learnmore']}}

Please note: We are reviewing Western blot images included in the antibody testing data in our catalog, including those provided by third parties. Unless expressly labeled or annotated as “raw-unedited”, Western blot images included in the antibody testing data in our catalog may have been edited, optimized or otherwise adjusted for presentation.
Product Details
14461-1-AP
Species Reactivity
Host/Isotype
Class
Type
Immunogen
Conjugate
Form
Concentration
Amount
Purification
Storage buffer
Contains
Storage conditions
Shipping conditions
Product Specific Information
This antibody is specific to AMH.
Immunogen sequence: GLALTLQPR GEDSRLSTAR LQALLFGDDH RCFTRMTPAL LLLPRSEPAP LPAHGQLDTV PFPPPRPSAE LEESPPSADP FLETLTRLVR ALRVPPARAS APRLALDPDA LAGFPQGLVN LSDPAALERL LDGEEPLLLL LRPTAATTGD PAPLHDPTSA PWATALARRV AAELQAAAAE LRSLPGLPPA TAPLLARLLA LCPGGPGGLG DPLRALLLLK ALQGLRVEWR GRDPRGPGRA QRSAGATAAD GPCALRELSV DLRAERSVLI PETYQANNCQ GVCGWPQSDR NPRYGNHVVL LLKMQARGAA LARPPCCVPT AYAGKLLISL SEERISAHHV PNMVATECGC R (211-560 aa encoded by BC049194)
Target Information
Anti mullerian hormone (AMH) is a member of the TGF beta superfamily. It is secreted as a homodimeric 140 kDa disulfide linked precursor that is cleaved to release the mature 30 kDa homodimer. Originally classified as a fetal testicular hormone that inhibits Mullerian duct development, AMH is expressed post natally by immature Sertoli cells, and to a lesser degree by granulosa cells. AMH plays a role in testicular differentiation and in the regulation of ovarian follicle growth.
For Research Use Only. Not for use in diagnostic procedures. Not for resale without express authorization.
Bioinformatics
Protein Aliases: AMH; Anti - Mullerian hormone (Mulerian inhibiting substance); Anti-Muellerian hormone; MIS; Muellerian-inhibiting factor; Muellerian-inhibiting substance; Mullerian inhibiting factor; Mullerian inhibiting substance
Gene Aliases: AMH; MIF; MIS
UniProt ID: (Rat) P49000, (Mouse) P27106
Entrez Gene ID: (Human) 268, (Rat) 25378, (Mouse) 11705

Performance Guarantee
If an Invitrogen™ antibody doesn't perform as described on our website or datasheet,we'll replace the product at no cost to you, or provide you with a credit for a future purchase.*
Learn more
We're here to help
Get expert recommendations for common problems or connect directly with an on staff expert for technical assistance related to applications, equipment and general product use.
Contact tech support